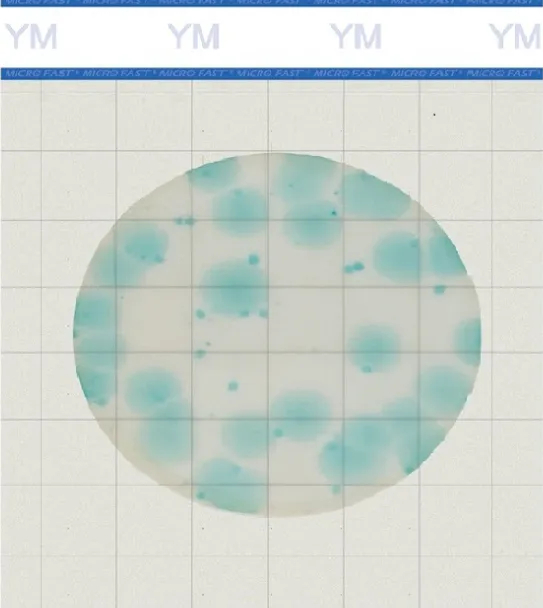
640_副本.jpg

2025-02-27 10:29瀏覽量:320
2025 年 2 月 24 日,中國出入境檢驗檢疫協會批準了《食品中霉菌和酵母快速檢測 測試片法》團體標準立項,該標準由山東美正生物科技有限公司牽頭起草。
?
本標準將基于測試片技術,建立適用于不同類型食品中霉菌和酵母快速檢測的方法體系,針對常規食品樣品和具有挑戰性的樣品(牛油果、蝦等),制定詳細的操作流程和驗收指南。
?
這一舉措彰顯了美正生物在微生物檢測領域的深厚技術積累和行業引領地位。
?
美正生物推出的MicroFast?Premium系列霉菌酵母測試片法是用一種預先制備的含有指示劑及冷水可溶性凝膠的培養基系統進行微生物培養的方法。培養基中含有霉菌和酵母生長的主要營養物質和功能性物質(如顯色底物、冷水可凝膠等)。
?
霉菌和酵母生長過程中代謝產生的酶與測試片中的顯色底物發生反應,釋放顯色基團,累積后信號放大,在可見光下顯示藍綠色菌落并被計數。最快2天可以出結果,節省人工提高效率,并可有效防止霉菌酵母檢驗過程的污染。
?
Premium系列測試片家族
